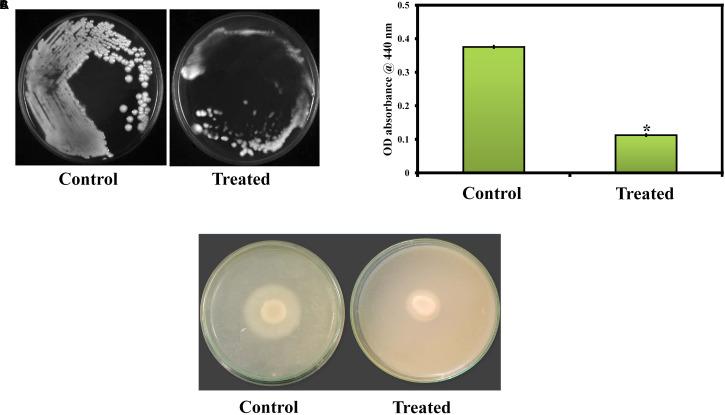
https://cdn.ncbi.nlm.nih.gov/pmc/blobs/ff81/7644646/f821554a83e2/fmicb-11-561298-g005.jpg

桑色素对致病性和毒力因子产生的抑制作用:体内和体外研究方法
Inhibitory Effect of Morin Against Pathogenicity and Virulence Factor Production: An and Approaches.
作者信息
Abirami Gurusamy, Alexpandi Rajaiah, Durgadevi Ravindran, Kannappan Arunachalam, Veera Ravi Arumugam
机构信息
Department of Biotechnology, School of Biological Sciences, Alagappa University, Karaikudi, India.
Department of Food Science and Technology, School of Agriculture and Biology, Shanghai Jiao Tong University, Shanghai, China.
出版信息
Front Microbiol. 2020 Oct 23;11:561298. doi: 10.3389/fmicb.2020.561298. eCollection 2020.
is considered an exclusive etiologic agent of candidiasis, a very common fungal infection in human. The expression of virulence factors contributes highly to the pathogenicity of . These factors include biofilm formation, yeast-to-hyphal transition, adhesins, aspartyl proteases, and phospholipases secretion. Moreover, resistance development is a critical issue for the therapeutic failure of antifungal agents against systemic candidiasis. To circumvent resistance development, the present study investigated the virulence targeted therapeutic activity of the phyto-bioactive compound morin against . Morin is a natural compound commonly found in medicinal plants and widely used in the pharmaceutical and cosmetic products/industries. The present study explicated the significant inhibitory potential of morin against biofilm formation and other virulence factors' production, such as yeast-hyphal formation, phospholipase, and exopolymeric substances, in . Further, qPCR analysis confirmed the downregulation of biofilm and virlence-related genes in upon morin treatment, which is in correspondence with the bioassays. Further, the docking analysis revealed that morin shows strong affinity with Hwp-1 protein, which regulates the expression of biofilm and hyphal formation in and, thereby, abolishes fungal pathogenicity. Moreover, the anti-infective potential of morin against -associated systemic candidiasis is confirmed through an approach using biomedical model organism zebrafish (). The outcomes of the study demonstrate that the morin treatment effectively rescues animals from infections and extends their survival rate by inhibiting the internal colonization of . Histopathology analysis revealed extensive candidiasis-related pathognomonic changes in the gills, intestine, and kidney of animals infected with , while no extensive abnormalities were observed in morin-treated animals. The results evidenced that morin has the ability to protect against the pathognomonic effect and histopathological lesions caused by infection in zebrafish. Thus, the present study suggests that the utilization of morin could act as a potent therapeutic medication for instigated candidiasis.
被认为是念珠菌病的唯一病原体,念珠菌病是人类非常常见的真菌感染。毒力因子的表达对其致病性有很大贡献。这些因素包括生物膜形成、酵母到菌丝的转变、黏附素、天冬氨酸蛋白酶和磷脂酶分泌。此外,耐药性的产生是抗真菌药物治疗系统性念珠菌病失败的关键问题。为了规避耐药性的产生,本研究调查了植物生物活性化合物桑色素针对其的毒力靶向治疗活性。桑色素是一种常见于药用植物中的天然化合物,广泛应用于制药和化妆品产品/行业。本研究阐明了桑色素对其生物膜形成和其他毒力因子产生(如酵母-菌丝形成、磷脂酶和胞外聚合物)具有显著的抑制潜力。此外,qPCR分析证实桑色素处理后其生物膜和毒力相关基因的下调,这与生物测定结果一致。进一步的对接分析表明,桑色素与Hwp-1蛋白具有很强的亲和力,该蛋白调节其生物膜和菌丝形成的表达,从而消除真菌致病性。此外,通过使用生物医学模式生物斑马鱼的方法证实了桑色素对相关系统性念珠菌病的抗感染潜力。该研究结果表明,桑色素治疗可有效拯救动物免受感染,并通过抑制其内部定植来延长其存活率。组织病理学分析显示,感染的动物鳃、肠道和肾脏出现广泛的念珠菌病相关特征性变化,而在桑色素处理的动物中未观察到广泛异常。结果证明,桑色素有能力预防斑马鱼感染引起的特征性效应和组织病理学损伤。因此,本研究表明,利用桑色素可作为治疗引发的念珠菌病的有效治疗药物。